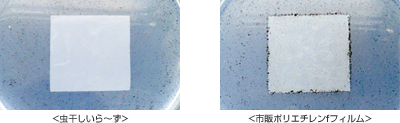
<虫干しいら～ず> <市販ポリエチレンfフィルム>

お役立ち商品紹介
虫干しいら~ず 3,300円(税込3,630円)
- ● 寸法:横920mm×縦430mm
- ● セット内容:虫干しいら~ず/ネームシール/ツマミシール
- ● 【保証期間】ご購入後5年間

ショッピングサイトからご注文いただけます。
>>鈴乃屋ジャパンコレクション 虫干しいら~ず

虫干しなどのお手入れや収納が面倒で、なかなかきものを着れない・・・
そんな方にもぴったりな、鈴乃屋の新商品「虫干しいら~ず」。
三重構造の特殊フィルムの袋にしまうだけ!脱酸素剤もいらないんです。
とにかく簡単なんです。
- ①
- きものをたとう紙で包み、「虫干しいら~ず」の中に入れます。
- ②
- ファスナーを端から端までしっかり密閉したら出来上がり!
付属のネームシールに収納物を記入して貼ってください。

- 《取り扱い上のご注意》
- ※密封されていない状態ですと効果が薄れます。
- ※突起物などによる外部からの穴開き、傷、破れには十分気を付けてください。
- ※着用した着物は、クリーニングをしてから収納・保管してください。
- ※長時間直射日光下での保管はしないでください。 紫外線カット加工はしていますが、色やけする可能性があります。
- ※絹素材特有の自然変色は防止できません。
- ※一般ゴミとして焼却処分できます。

「虫干しいら~ず」は、抗菌剤・抗酸化剤含有フィルム、ガスバリアフィルム、保護フィルムの
三層構造。ファスナーには完全密閉ダブルチャックを採用。
大切なきものを守ります。国際特許を取得した特殊なフィルム、プロガードを使用しています。

![]()
和服への虫食いで代表的な害虫といえば、ヒメカツオブシムシ。その供試虫を「虫干しいら~ず」と市販のポリエチレン袋に各々60匹入れて比較実験しました。 結果、14日経過ののち、ポリエステル袋のほうは生存率が高く、中には蛹化や孵化している個体も観察されました。 それに対し、「虫干しいら~ず」は試験開始後3~4日経過時点で、すでに死んでいたことが観察され、ほとんど虫食いの痕跡が見当たりませんでした。


「虫干しいら~ず」と市販のポリエチレンフィルムを、それぞれ黒こうじカビ溶液に浸して比較実験をしました。 1カ月後、市販のポリエチレンフィルムのほうは全体がカビに覆われましたが、「虫干しいら~ず」にはカビの増殖がほとんど見受けられませんでした。